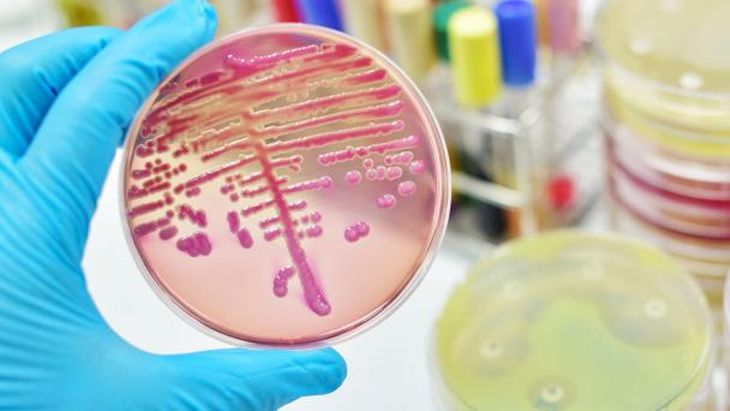

La Cofepris encendió las alarmas sanitarias en todo el país tras anunciar el retiro inmediato de un popular shampoo que se vendía en supermercados y tiendas de México. La autoridad explicó que el producto presenta un grave riesgo para la salud debido a su contaminación con una bacteria altamente peligrosa.
Retiran popular shampoo de todos los supermercados de México: está contaminada de una bacteria que provoca infecciones
Cofepris ordenó retirar de supermercados en México un shampoo contaminado con Klebsiella oxytoca que puede causar infecciones graves en la salud.
-
COFEPRIS emite alerta sanitaria por falsificación de tequila y whiskey: cuáles son todas las marcas afectadas
-
Resultados del Tris: todos los ganadores de hoy, miércoles 3 de junio 2026
Estos shampoo son muy populares en México y contienen ingredientes que dañan el cuero cabelludo: Profeco dice que no las compres
De acuerdo con el organismo, el artículo en cuestión se encontraba disponible en varias cadenas comerciales, lo que aumenta la preocupación entre los consumidores que ya lo adquirieron. La Comisión Federal para la Protección contra Riesgos Sanitarios pidió extremar precauciones y evitar el uso del shampoo bajo cualquier circunstancia.
El anuncio generó gran revuelo en la opinión pública, pues el producto retirado pertenece a una marca reconocida en el mercado de cuidado capilar. Lo que parecía un insumo de belleza común se convirtió en un riesgo sanitario que ahora obliga a miles de personas a estar atentas a las indicaciones de las autoridades.
Cofepris: el shampoo que fue retirado de los supermercados por contaminación
La Cofepris informó que la empresa Henkel Capital, S.A. de C.V. inició el retiro del Shampoo Totale de la marca Tec Italy, específicamente en su presentación de 1 litro con el número de lote 1G27542266. El motivo es la posible contaminación con la bacteria Klebsiella oxytoca, la cual puede ocasionar infecciones severas.
La autoridad sanitaria precisó que el retiro se limita únicamente a este lote, aunque no descartó que, en caso de obtener evidencia sobre otros productos afectados, se amplíe la medida. Por lo pronto, la indicación es clara: inmovilizar de inmediato cualquier existencia del shampoo y suspender su venta.
A la población en general, la Cofepris recomendó abstenerse de usar el shampoo y revisar si cuentan con la presentación señalada. En caso de haberlo adquirido, se sugiere no aplicarlo en ninguna circunstancia y ponerse en contacto con la empresa responsable o con la autoridad sanitaria.
Para los distribuidores y establecimientos, el llamado es a suspender su comercialización, inmovilizar los lotes afectados y notificar a Henkel Capital, así como a la Cofepris, para dar seguimiento al proceso de retiro.
Los peligros de la bacteria Klebsiella oxytoca
La bacteria Klebsiella oxytoca representa un riesgo serio para la salud, especialmente en personas con defensas bajas o con sistemas inmunológicos comprometidos. Su contacto con piel, ojos o vías respiratorias puede desencadenar distintos tipos de infecciones.
Los síntomas varían desde cuadros relativamente leves, como diarrea, hasta complicaciones graves como bacteriemia o incluso meningitis. En escenarios más críticos, esta bacteria puede poner en riesgo la vida del paciente si no se atiende a tiempo.
Por ello, la presencia de Klebsiella oxytoca en un producto de uso cotidiano como un shampoo resulta particularmente alarmante. Al ser aplicado directamente sobre el cuero cabelludo y estar en contacto con la piel, la posibilidad de una infección aumenta de manera considerable.
La Cofepris subrayó que esta medida es preventiva y busca proteger a los consumidores antes de que se registren incidentes de salud relacionados con el uso del shampoo contaminado. Asimismo, reiteró que cualquier persona que haya usado el lote afectado y presente síntomas inusuales debe acudir de inmediato a un médico y notificar a las autoridades sanitarias.
- Temas
- Cofepris